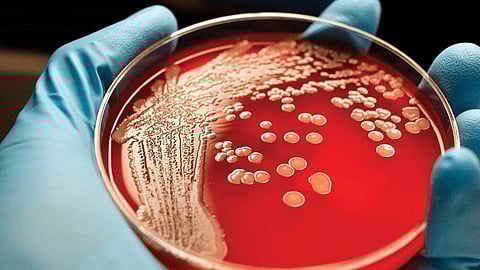

سرطان الدم
كشفت صحة الرياض أعراض وعوامل خطورة الإصابة بسرطان الدم.
وأشارت صحة الرياض، عبر حسابها الرسمي على تويتر، أن أعراض سرطان الدم تختلف من مريض لآخر ولكن قد تحدث واحدة من الأعراض الآتية والتي تتمثل في:
ارتفاع درجة الحرارة
تعرق الليلي
التهابات مكررة
فقدان الوزن
الصداع
ألم في المفاصل
نزيف دموي
كدمات على الجلد
تضخم الغدد الليمفاوية
الإعياء
كما ذكرت صحة الرياض عوامل الخطورة للإصابة بسرطان الدم بسبب:
التعرض لإشعاع عالي الطاقة من قنبلة ذرية أو مصنع للطاقة النووية
التعرض لعلاج كيميائي أو إشعاعي.
اعتلالات الدم.
الاختلالات الوراثية كمتلازمة داون.
بعض أنواع الفيروسات قد تسبب أورامًا كالتهاب الكبد الوبائي من نوع ب وكذلك فيروس الإيدز.
إصابة أحد أفراد الأسرة بسرطان الدم مسبقًا وهذا نادر الحدوث.